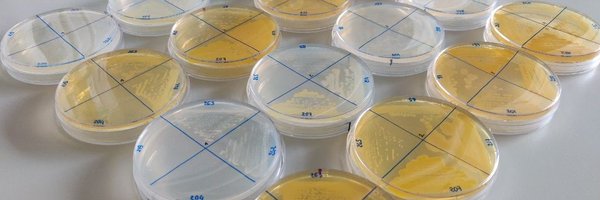
Lau_cms Profile Banner

Laura Camus
@Lau_cms
Followers
309
Following
891
Media
18
Statuses
200
🦠 Post-doctoral microbiologist in team Heilbronner and CMFI / 🔎 Interspecies interactions within human microbiotas / 🔊 Scientific communication
Tübingen, Germany
Joined April 2018
Thrilled to share the preprint from my main postdoc project with @SimonHeilbronn1 and @CoE_CMFI ! 🎉 We found that tyrosine availability can shape Staphylococcus aureus colonization in the nose by mediating its interactions with commensal species 🦠 https://t.co/7GRp3A8YKL
2
7
18
Like every year, the @CoE_CMFI has a little something for the Christmas season 🎄 I've found one of the hidden Saint-Nicolas in the building: did you know that chocolate helps you focus when writing? 😇🍫 #CMFInikolaus @uni_tue
0
0
9
Der CMFI Nikolaus war an der Universität Tübingen unterwegs und hat für die Studierenden und Mitarbeitenden Schokonikoläuse auf dem gesamten Campus versteckt. Sein Versteckspiel haben wir für euch gefilmt. #Nikolaus
https://t.co/8e5COExiNO
0
1
4
Throwback Thursday: Around this time in 2023, we were rotating to prepare everything for our CMFI 2023 conference @uni_tue. Over 350 people from all over the world came to Tübingen for fruitful and intensive exchange It was a great success and fun! https://t.co/lXIBG94Zn5
1
2
4
Save the date for AdvMicro25! 🥳🥳🥳The 1st International Conference on Advancements of Microbiology. The relevance of Microbes in Tackling threats to Health and Environment next year in Warsaw April 7-9th 2025. For more info go to https://t.co/14O238anDM 😊😃 Please RT!
0
19
31
Yesterday was the final day of the #ISSSI2024 ! After many interesting presentations and enriching discussions, I now have a few days left to visit Perth 🌏 Direction Banff, Canada for the 2026 edition 🍁
0
0
9
Barbara Kahl delivered an excellent talk today titled, ‘Prevalence, persistence and Adaption of S. aureus Within the Airways of Cystic Fibrosis Patients’ at #ISSSI2024
0
1
14
Two months ago I presented my project at the DGHM/VAAM conference in Würzburg 🇩🇪 And now, @SimonHeilbronn1 and @AndreasPeschel1 gave me the opportunity to fly to Australia to speak at the #ISSSI2024 🇦🇺 I can't wait to discover this symposium and Perth!
3
1
45
I am really happy to see this published! Great work lead by Fabian Grein! @DZIF_, @TRR261, @CoE_CMFI. A special bacteriocin kills Corynebacteria in the nasal microbiome! https://t.co/NPZLS3tdeM
academic.oup.com
Abstract. Many bacteria produce antimicrobial compounds such as lantibiotics to gain advantage in the competitive natural environments of microbiomes. Epil
3
6
46
Meet our excellent junior group leader @Arnaud_Kengmo Tchoupa! @CoE_CMFI
#Excellence in #Tübingen – we enable you to pave new paths. More information about infrastructure, funding and cooperations: Explore your opportunities at the @uni_tue on our new #careers site: https://t.co/YsqKm01mC8 📽️ZfM/Universität Tübingen #research, #exstra, #karriere
0
5
20
CMFI celebrates #InternationalWomensDay! Our labs would stand still without the incredible women at CMFI! In every department, at all career levels, they drive innovation and inspire future generations. 365 - days - a - year. #InspireInclusion #WomenInSTEM #Empowerment #IWD24
2
3
20
Staph. lugdunensis produces lugdunin to eliminate nasal #S.aureus. Why are less than 10% of humans colonized by S. lugdunensis? It need specific support from other #microbiome members. With Ralf Rosenstein, Benjamin Torres, @SimonHeilbronn1, Bernhard Krismer, @CoE_CMFI @DZIF_
Siderophore piracy enables the nasal commensal Staphylococcus lugdunensis to antagonize the pathogen Staphylococcus aureus https://t.co/a4rlRtK8yv
#bioRxiv
2
17
66
[RECRUTEMENT] L'équipe StaPath (Pathogénèse des #Staphyloccoques) et l'@IUTLyon1 recrutent un/e maître de conférences Plus d'informations ➡️ https://t.co/4EugKOPkxr
0
5
7
How nature can minimize collateral damage by broad-spectrum antibiotics: We describe the microbiome-derived antimicrobial epifadin, compensating broad activity with very short half life! With Bernhard Krismer, @hbroetz @StephanieGrond @tilmweber, many others. @CoE_CMFI @DZIF_
NEW RESEARCH! 👃🦠 A nasal commensal produces a broad-spectrum, short-lived antimicrobial peptide polyene that inhibits S. aureus in vitro and in vivo @AndreasPeschel1 & colleagues https://t.co/UCZ4DCgSEY
2
16
77
After this first snowy weekend of the year, I'm happy to announce that I am staying one more year in Tübingen ❄️ The CMFI cluster has extended my postdoc funding to enable me to finalize my projects 🎉 So thank you @CoE_CMFI and @SimonHeilbronn1 !
1
0
36
First edition of the Staphosium conference by the @GTStaph_SFM : a very rich scientific program and an outstanding organization 💯 And first oral presentation of my postdoc project 🎉 Thank you!
0
1
11
How S. aureus interacts with the endothelium in endovascular infections @CoE_CMFI @DZIF_ Wall Teichoic Acid Mediates Staphylococcus aureus Binding to Endothelial Cells via the Scavenger Receptor LOX-1 | ACS Infectious Diseases
pubs.acs.org
The success of Staphylococcus aureus as a major cause for endovascular infections depends on effective interactions with blood-vessel walls. We have previously shown that S. aureus uses its wall...
1
14
45
A collaborative work connecting nicely bioinformatics and wet lab! 💻 🧪 Check our latest paper on metabolic models of Corynebacterium striatum 👇
Metabolic models are promising tools to predict phenotypic characteristics of bacteria but their predictions are rarely put to the test in the lab. Here we do it. Nice work together with @dr_drae, @Lau_cms, G. Dübel and lead by @FamBaeuerle! @CoE_CMFI
0
1
9